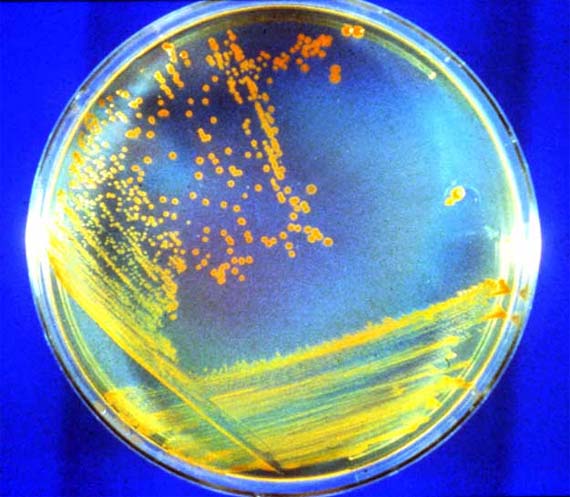

День Соборности Украины.
В Польше отмечают День дедушек, Grandfather's Day! В этот день внуки заходят к дедушкам и бабушкам в гости, дарят им подарки и цветы.
1630 Английские колонисты впервые пробуют поп корн, их угощает индеец Кводекуаин.
1690 году индейское племя ирокезов подписало мирный договор с британскими властями в Северной Америке.
1775 году евреи изгнаны из Варшавы.
1786 Екатерина Великая повелевает россиянам подписывать бумаги словом "верноподданный" вместо "раб".
1889 В Вашингтоне образуется одна из первых звукозаписывающих фирм.
1931 году английские врачи объявили об открытии метода иммунизации против полиомиелита.
1939 году в Колумбийском университете США впервые расщеплен атом урана.
Улыбнемся сегодня День исследования блокнотных записей:)
22 января родились:
1561 Фрэнсис Бэкон, английский философ, родоначальник английского материализма.
1572 По одной из версий в этот день в Лондоне родился Джон Донн английский поэт и богослов. Был настоятелем лондонского собора Святого Павла и остался в веках не только как литератор, но и как проповедник, умевший обращать в истинную веру любых еретиков и скептиков.
1592 Пьер Гассенди, французский философ, священник, комментатор эпикурейства.
1690 Николя Ланкре, французский художник "Зима", "Французский актер".
1729 Готхольд Лессинг, немецкий драматург, основоположник немецкой литературы "Мисс Сара Сампсон", "Натан Мудрый".
1775 Андре Мари Ампер, французский ученый.
1788 Джордж Ноэль Гордон Байрон, английский поэт.
1849 Август Стриндберг, шведский писатель, драматург.
1875 Дэвид Уорк Гриффит, американский кинорежиссер.
1889 Баумайстер Вилли, один из наиболее значительных немецких художников абстракционистов.
1890 Григорий Ландсберг, русский физик, автор "Элементарного учебника физики".
1891 Франц Александр, венгерский психоаналитик, основатель психосоматической медицины.
1892 Марсель Дассо Marcel Dassauln, французский авиаконструктор создатель "Миражей".
1896 Норман Гилрой, первый австралийский кардинал.
1908 Лев Давидович Ландау, физик теоретик, академик, лауреат Нобелевской премии.
1935 Сэм Кук, американский пионер рок н ролла. В 1986 в числе первых был избран в Зал славы рок н ролла.
1935 Александр Владимирович Мень, священник.
ПРИТЧИ СОЛОМОНА XXII
1 Доброе имя лучше большого богатства, и добрая слава лучше серебра и золота.
2 Богатый и бедный встречаются друг с другом: того и другого создал Господь.
3 Благоразумный видит беду, и укрывается; а неопытные идут вперед, и наказываются.
4 За смирением следует страх Господень, богатство и слава и жизнь.
5 Терны и сети на пути коварного; кто бережет душу свою, удались от них.
6 Наставь юношу при начале пути его: он не уклонится от него, когда и состарится.
7 Богатый господствует над бедным, и должник делается рабом заимодавца.
8 Сеющий неправду пожнет беду, и трости гнева его не станет. [Человека, доброхотно дающего, любит Бог, и недостаток дел его восполнит.]
9 Милосердый будет благословляем, потому что дает бедному от хлеба своего. [Победу и честь приобретает дающий дары, и даже овладевает душею получающих оные.]
10 Прогони кощунника, и удалится раздор, и прекратятся ссора и брань.
11 Кто любит чистоту сердца, у того приятность на устах, тому царь друг.
12 Очи Господа охраняют знание, а слова законопреступника Он ниспровергает.
13 Ленивец говорит: "лев на улице! посреди площади убьют меня!"
14 Глубокая пропасть уста блудниц: на кого прогневается Господь, тот упадет туда.
15 Глупость привязалась к сердцу юноши, но исправительная розга удалит ее от него.
16 Кто обижает бедного, чтобы умножить свое богатство, и кто дает богатому, тот обеднеет.
17 Приклони ухо твое, и слушай слова мудрых, и сердце твое обрати к моему знанию;
18 потому что утешительно будет, если ты будешь хранить их в сердце твоем, и они будут также в устах твоих.
19 Чтобы упование твое было на Господа, я учу тебя и сегодня, и ты помни.
20 Не писал ли я тебе трижды в советах и наставлении,
21 чтобы научить тебя точным словам истины, дабы ты мог передавать слова истины посылающим тебя?
22 Не будь грабителем бедного, потому что он беден, и не притесняй несчастного у ворот,
23 потому что Господь вступится в дело их и исхитит душу у грабителей их.
24 Не дружись с гневливым и не сообщайся с человеком вспыльчивым,
25 чтобы не научиться путям его и не навлечь петли на душу твою.
26 Не будь из тех, которые дают руки и поручаются за долги:
27 если тебе нечем заплатить, то для чего доводить себя, чтобы взяли постель твою из под тебя?
28 Не передвигай межи давней, которую провели отцы твои.
29 Видел ли ты человека проворного в своем деле? Он будет стоять перед царями, он не будет стоять перед простыми.

Читаем детям
Мери Бетчелор. Невеста для Исаака
Бытие 24
Прошли годы, Исаак вырос и возмужал. Его мать Сарра умерла, дожив до глубокой старости. Авраам тоже был уже очень стар, но чувствовал себя счастливым, зная, что его сын Исаак унаследует чудесное Божье обетование и станет прародителем великого народа.
Однажды Авраам позвал своего раба, старшего над всеми слугами, и сказал ему:
Пришло время найти жену моему сыну. Я не желаю, чтобы он женился на ханаанейке. Поклянись, что ты отправишься ко мне на родину и привезешь оттуда невесту для Исаака.
Путь туда долог, ответил слуга. И может случиться, что девушка не захочет отправиться со мной в неведомые ей края. Не лучше ли самого Исаака отправить в Месопотамию?
Ни за что! твердо сказал Авраам. Господь привел меня в эту землю и обещал отдать ее моим потомкам. Исаак должен жить здесь. Ты же иди и найди для него невесту. Если же девушка, которую ты выберешь, откажется идти с тобой, считай себя свободным от клятвы.
И вот раб снарядил караван из десяти верблюдов и отправился в Месопотамию. Наконец, однажды вечером, он остановился у колодца близ того города, где прежде жил Авраам. Раб не поспешил в город он преклонил колени и стал молиться:
Господи, Боже господина моего Авраама! Помоги мне найти хорошую жену для Исаака. Я знаю, что скоро девушки придут сюда за водой. Прошу Тебя, пусть девушка, которая даст напиться мне и предложит воды для моих верблюдов, будет именно той девушкой, которую Ты избрал в жены Исааку.

Верующие женщины Ежедневное исповедание: спасение
"...Который отдал Себя Самого за грехи наши, чтобы избавить нас от настоящего лукавого века, по воле Бога и Отца нашего...", Галатам 1:4
Отец, славлю и благодарю Тебя за то, что Иисус был готов отдать Свою жизнь, чтобы спасти и освятить меня, избавить меня от греха этого мира. Ты поднял меня над всякой плотской завистью и похотью, чтобы я могла заниматься Твоими делами, а не делами этого мира. Когда Ты задумывал именно мою жизнь, Ты вложил в нее всё самое дивное и прекрасное, что только можешь сделать для меня!


 Что делают люди, когда они сталкиваются с чудовищем? Прежде всего они пытаются его сфотографировать. Джеффри Евгенидес
Что делают люди, когда они сталкиваются с чудовищем? Прежде всего они пытаются его сфотографировать. Джеффри Евгенидес
